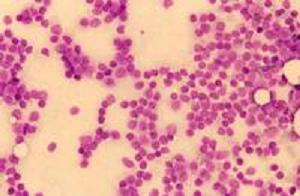
QUICHA, Cocker Spaniel, weiblich, 4 jährig

Vorgestellt wegen vermindertem Allgemeinzustand, reduziertem Appetit und Erbrechen.
In der Blutuntersuchung wird ein stark erhöhter Blut-Calciumwert festgestellt. Ansonsten sind die Blutwerte von „Torro“ normal. Aufgrund der leichten Vergrösserung mehrerer Lymphknoten und der starken Erhöhung des Calciumwertes wird die Verdachtsdiagnose eines Lymphoms (Lymphdrüsenkrebs) gestellt. Weitere mögliche Krankheiten, welche eine Erhöhung des Calciumwertes bewirken, werden vorerst diagnostisch nicht weiter verfolgt.
Aus drei vergrösserten Lymphknoten wird am wachen Tier mittels einer schmerzlosen Feinnadelaspiration eine Gewebeprobe entnommen. Aufgrund des starken Krebsverdachtes wird ein Bruströntgen durchgeführt, bei dem eine Vergrösserung der Brustbein-Lympknoten festgestellt wird. Ein Ultraschall der Bauchhöhle zeigt verschiedene, echoarme Knoten in der Milz; die Bauchlymphknoten erscheinen aber normal. Die Untersuchung der Gewebeproben in einem externen Labor bestätigt den Verdacht, dass „Torro“ an einem Lymphdrüsenkrebs leidet.

Währenddem auf den zytologischen Bericht gewartet wird, erhält der Hund intravenöse Infusionen mit Kochsalzlösung sowie ein harntreibendes Mittel, um den gefährlich hohen Calciumwert zu senken. Zudem erhält „Torro“ Medikamente gegen das Erbrechen.
Nach Eintreffen der Cytologie-Resultate werden die Behandlungsoptionen mit der Besitzerin besprochen. Sie entscheidet sich für die Durchführung einer Chemotherapie.
2 Tage nach der erstmaligen Konsultation wird die Kombinations-Chemotherapie begonnen. In einer ersten Phase (Induktionsphase) werden dem Hund drei verschiedene Medikamente verabreicht: zwei davon können von der Besitzerin in Tablettenform verabreicht werden, eines davon wird jede Woche intravenös in der Praxis appliziert. Jede Woche wird eine Blutentnahme durchgeführt, um ein zu tiefes Absinken der weissen Blutkörperchen aufgrund der Chemotherapie rechtzeitig erkennen zu können. Schon kurz nach Beginn der Chemotherapie geht es dem Hund deutlich besser und der Blutcalciumwert ist wieder im Normalbereich. Die Lymphknoten haben sich mit Ausnahme eines Brustlymphknotens auf ihre normale Grösse verkleinert; auf einem Röntgenbild ist sichtbar, dass auch die Brustbein-Lymphknoten auf ihre normale Grösse geschrumpft sind. Als Nebenwirkungen ist einzig eine vergrösserte Trinkmenge festzustellen. Da sich „Torro“ nur in einer sogenannten „Teilremission“ befindet, werden zur Chemotherapie-Intensivierung 2 weitere Medikamente eingesetzt, welche den einen vergrössert gebliebenen Lymphknoten weiter kleiner werden lassen.
Nach sechs Wochen wird die Induktionsphase beendet und die Erhaltungsphase begonnen, in der „Torro“ in unterschiedlichen Abständen 3 verschiedene Medikamente in Tablettenform erhält. Monatliche Kontrollen in der Praxis stellen sicher, dass Probleme und Nebenwirkungen frühzeitig erkannt werden können. Dieses Behandlungsschema wird so lange aufrechterhalten, wie die Remission anhält.



Lymphom (Lymphkrebs) ist eine der häufigeren Krebsarten bei Hunden und Katzen. Beim Hund sind gewisse Rassen (Boxer, Basset, Labrador Retriever und andere) und Linien häufiger befallen als der Durchschnitt. Grundsätzlich kann der Krebs in jedem Organ auftreten, in dem Lymphozyten (ein Typ Abwehrzellen) vorhanden sind (z.B. Auge, Hirn, Haut, Darm etc.). Beim Hund ist die multizentrische Form, bei welcher Organe wie Lymphknoten, Milz, Knochenmark und Leber betroffen sind, am häufigsten. Da bei dieser Krebsform sehr oft mehrere Lymphknoten oder Organe befallen werden, ist die chirurgische Entfernung des Krebses häufig keine Option. Neben schlechtem Allgemeinzustand, vermindertem Appetit, möglicherweise Fieber und Gewichtsverlust können Veränderungen des Blutbildes auftreten. Da der Krebs eine hormonähnliche Substanz bildet („Parathormone–related Protein“), werden bei vielen Hunden erhöhte Calciumspiegel im Blut festgestellt, welche ihrerseits Krankheitssymptome verursachen können.
Zur Diagnose des Krebses reicht häufig die einfach durchzuführende Feinnadelaspiration. Falls die Diagnose nicht sicher stellbar ist, wird eine Biopsie (Gewebeentnahme en bloc) des betroffenen Organes durchgeführt. Zur Diagnose- und Prognosestellung gehört meist auch ein sogenanntes „Staging“, bei welchem abgeklärt wird, in welchen Organen der Tumor alles vorhanden ist.
Bei „Torro“ kommen zwei verschiedene Behandlungsformen in Frage: Cortison (Prednisolon) alleine, oder aber in Kombination mit anderen Medikamenten (eigentliche Chemotherapie). Die Vorteile von Cortison als alleiniges verwendetes Medikament liegen im tiefen Preis, dem geringen Aufwand (keine regelmässigen Kontrollen notwendig) und den geringer ausfallenden Nebenwirkungen (Durchfall, Infekte, Erbrechen). Dafür sind die Erfolgsaussichten beim Einsatz einer Kombinationschemotherapie deutlich besser (obwohl auch hier der Krebs nicht endgültig besiegbar ist): Während Prednisolon alleine in etwa 50% der Hunde eine Remission (ein vorübergehendes Verschwinden des Krebses) bewirkt, welche durchschnittlich ca. 2 Monate anhält, bewirkt das bei „Torro“ verwendete Chemotherapieprotokoll bei ca. 70% der Hunde eine Remission, welche im Schnitt ein halbes Jahr anhält. Bei beiden Behandlungsarten ist in der Regel nicht eine abschliessende Heilung möglich. Es sind diverse Chemotherapie-Protokolle bekannt, welche je nach Patient, finanziellen Möglichkeiten und Besitzerwünschen einsetzbar sind.
Beim Menschen können während einer Chemotherapie teilweise massive Nebenwirkungen (schlechtes Befinden, Anfälligkeit gegen Infekte, Durchfall, Haarverlust, Appetitverlust etc) auftreten. Dies ist bei Hunden meistens nicht der Fall; die Tiere tolerieren den massierten Medikamenteneinsatz meistens problemlos und zeigen ein gutes Allgemeinbefinden. Eine Chemotherapie ist deshalb – gerade beim vergleichsweise gut behandelbaren Lymphom – ethisch durchaus vertretbar. Bei einer entsprechenden Therapie ist jedoch der recht hohe finanzielle Einsatz und der Umstand der nur temporären „Heilung“ des Tieres zu berücksichtigen.
© Dr. med. vet. P. Müller / Lyssbachvet